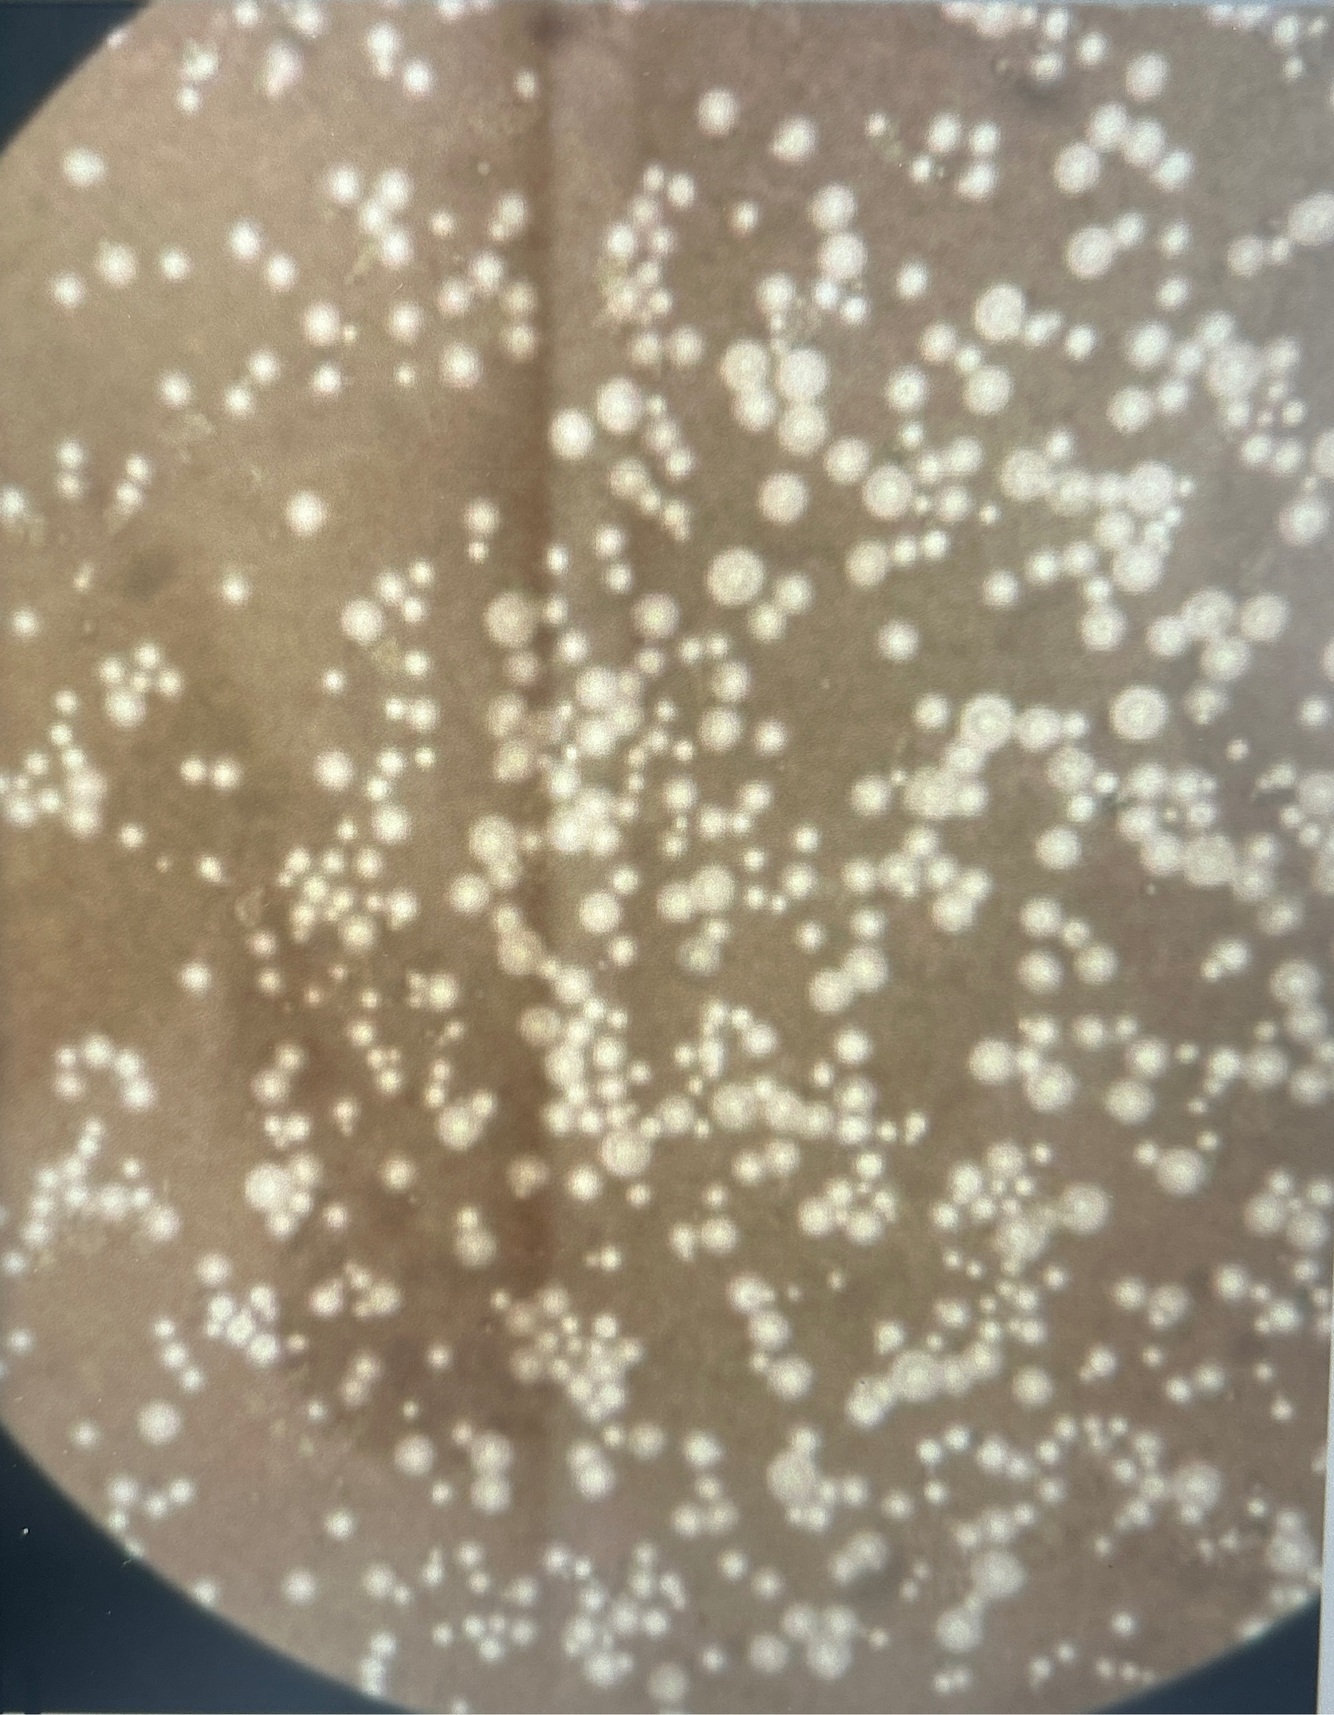

Qual diagnóstico?

Estruturas leveduriformes uniformes em formato de limão, com parede espessa e birrefringente
Agente: Lacazia loboi


Leveduras agrupadas e em aspecto catenular
Infiltrado granulomatoso
Lobomicose
Cite 5 agentes do eumicetoma?
Madurella myceyomatis
M. Grisea
Nigronana mackinonii
Acremonium
Scedosporium apiospermum
Actinomicetoma ou eumicetoma?

Eumicetoma

6 agentes da Actinomicetoma
Nocardia brasiliensis
Nocardia asteroides
Nocardia caviae
Actinomadura madurae
Actinimadura pelletieri
Streptomyces somaliensis
Actinomicetoma ou eumicetoma?

Actinomicetoma por Nocardia
Superfície mais homogênea

Actinomicetoma ou eumicetoma?

Actinomicetoma por Nocardia
Superfície mais homogênea

Qual nome da reação antígeno anticorpo que acontece ao redor do grão?
Fenômeno de Splendore-Hoeppli
Qual agente causador do actinomicose endógeno?
Actinomyces israelli (anaeróbico e gram +)

3 agentes da botriomicose
S. Aureus
Pseudomonas aeruginosa
Escherichia coli

Quais achados no AP da botriomicose?
Grão lobulares de bactérias não filamentosas
Infiltrado granulomatoso

Qual agente do actinomicetoma tem grãos vermelhos?
Actinomadura pelletieri

Quais tipos de albinismo oculocutaneo tipo 1 e quais diferenças?
1A: mutação completa do gene da tirosinase associada a perda total da pigmentação
1B: perda parcial da atividade da tirosinase
Qual mutação ocorre no albinismo oculocutâneo 2?
Gene P do compromisso 15

Qual nome dessa vesícula e qual agente?

Esporângio
Mucor
Como diferenciar o Rhizopus do Mucor?
Rhizopus tem rizóides (raizes) e Mucor não

Qual agente?

Syncephalastrum racemosum

Quais são as características das zigomicoses?

Hifas largas e tortuosas, com ramificação em ângulo reto, com pouca ou nenhuma septaçao (cenocíticas)
Quais os 3 principais causadores de mucormicose?
Mucor
Rhizopus
Lichtheimia

Qual diagnóstico?
Criptococose
Leveduras capsuladas
Qual diagnóstico?

Células de leveduras apresentando cápsula

Qual agente e qual doença?

Conidiobolus
Entomoftoromicose
Como chama a forma de esporotricose que há acometimento da conjuntiva + linfonodomegalia?
Síndrome oculoglandular de Parinaud
Qual diagnóstico?

Sporothrix sp
Hifas hialinas, separadas, ramificadas
Conidios ovalados dispostos “em formato de margarida”












































































